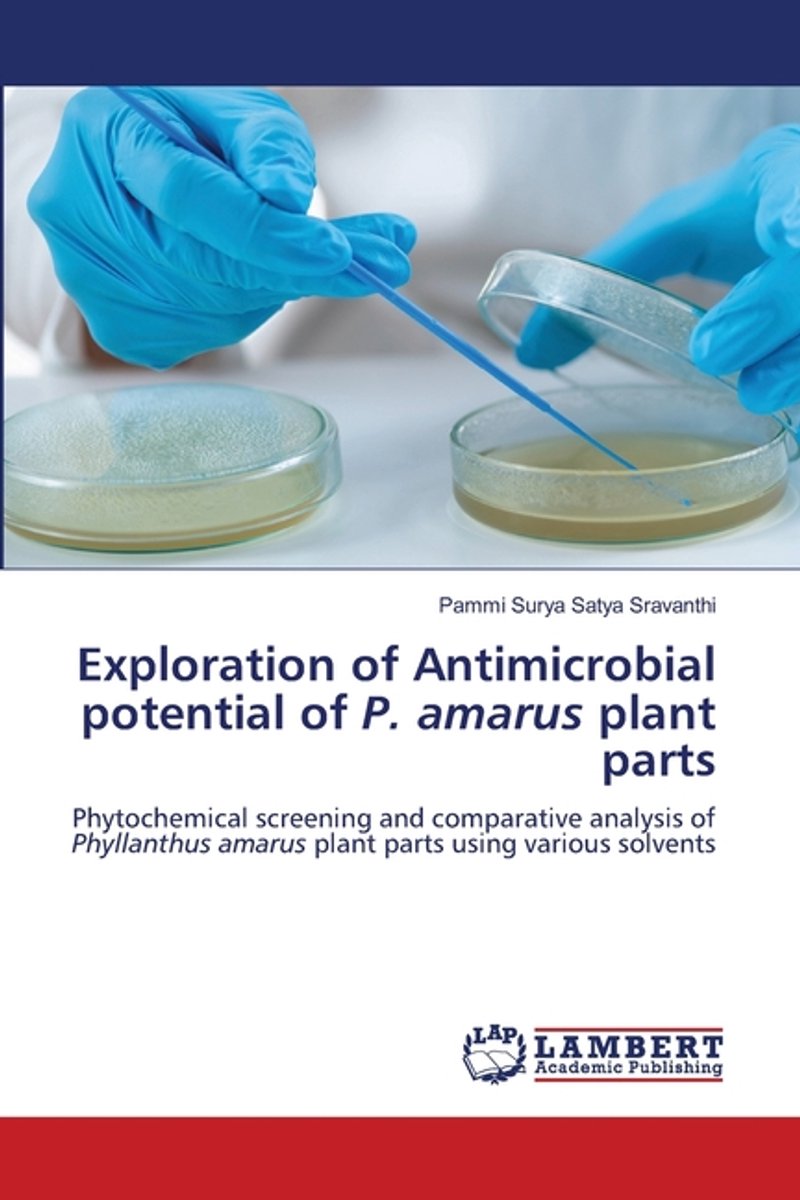

We hebben 2 boeken gevonden van de auteur Pammi Surya Satya Sravanthi
Hieronder vindt u een lijst met alle gevonden boeken van de auteur Pammi Surya Satya Sravanthi.
De meest gevonden boeken zijn Francisco Mbome en Exploration Of Antimicrobial Potential Of P. Amarus Plant Parts.
De meest gevonden boeken zijn Francisco Mbome en Exploration Of Antimicrobial Potential Of P. Amarus Plant Parts.
Sorteer op: